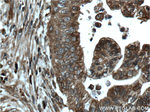
CNPY2/MSAP Antibody in Immunohistochemistry (Paraffin) (IHC (P))

Search
Proteintech
CNPY2/MSAP Polyclonal Antibody
{{$productOrderCtrl.translations['antibody.pdp.commerceCard.promotion.promotions']}}
{{$productOrderCtrl.translations['antibody.pdp.commerceCard.promotion.viewpromo']}}
{{$productOrderCtrl.translations['antibody.pdp.commerceCard.promotion.promocode']}}: {{promo.promoCode}} {{promo.promoTitle}} {{promo.promoDescription}}. {{$productOrderCtrl.translations['antibody.pdp.commerceCard.promotion.learnmore']}}
产品信息
14635-1-AP
种属反应
已发表种属
宿主/亚型
分类
类型
抗原
偶联物
形式
浓度
规格
纯化类型
保存液
内含物
保存条件
运输条件
产品详细信息
This antibody is specific to CNPY2.
Immunogen sequence: MKGWGWLAL LLGALLGTAW ARRSQDLHCG ACRALVDELE WEIAQVDPKK TIQMGSFRIN PDGSQSVVEV PYARSEAHLT ELLEEICDRM KEYGEQIDPS THRKNYVRVV GRNGESSELD LQGIRIDSDI SGTLKFACES IVEEYEDELI EFFSREADNV KDKLCSKRTD LCDHALHISH DEL (1-182 aa encoded by BC065015)
靶标信息
CNPY2 is positive regulator of neurite outgrowth by stabilizing myosin regulatory light chain (MRLC). It prevents MIR-mediated MRLC ubiquitination and its subsequent proteasomal degradation.
仅用于科研。不用于诊断过程。未经明确授权不得转售。
生物信息学
蛋白别名: canopy 2 homolog; MIR-interacting saposin-like protein; NSAP; Protein canopy homolog 2; Putative secreted protein ZSIG9; Transmembrane protein 4; unnamed protein product
基因别名: 5330432A10Rik; AW229003; CNPY2; D10Bwg1546e; HP10390; MSAP; TMEM4; UNQ1943/PRO4426; ZSIG9
UniProt ID: (Human) Q9Y2B0, (Mouse) Q9QXT0
Entrez Gene ID: (Human) 10330, (Mouse) 56530, (Rat) 685814